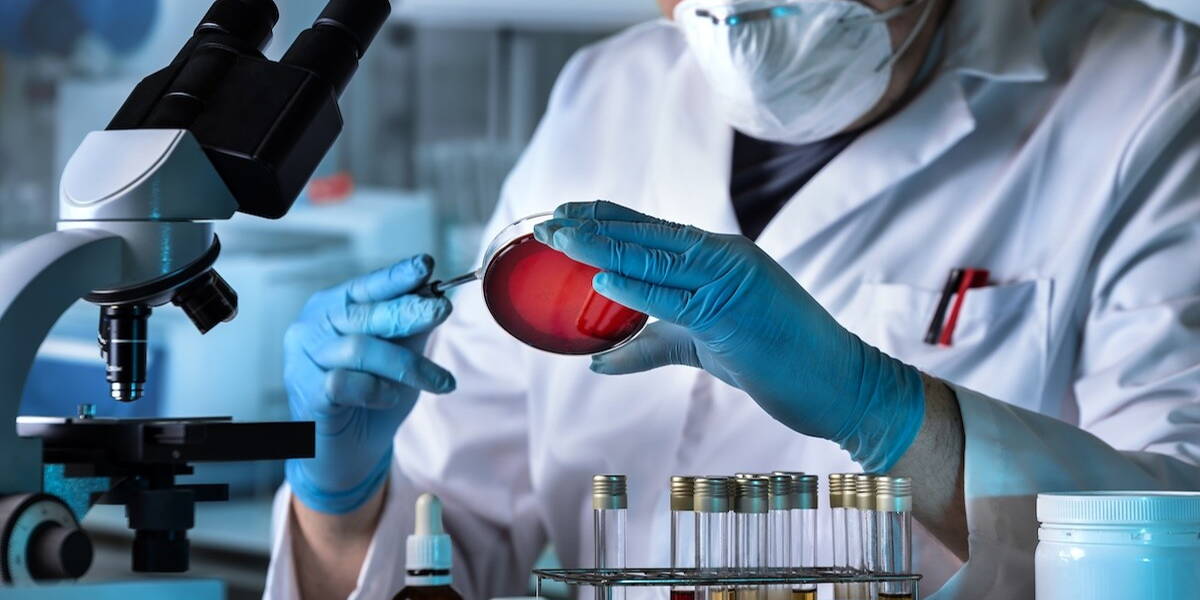

Na jaren van voorbereiding is in juni 2025 het Europese One Health AMR-partnerschap officieel van start gegaan. In dit programma slaan 53 organisaties uit 30 landen de handen ineen om de komende tien jaar de strijd tegen antimicrobiële resistentie (AMR) te versterken. AMR wordt wereldwijd beschouwd als een groeiende bedreiging die vraagt om directe actie: van het ontrafelen van biologische resistentiemechanismen tot het ontwikkelen van nieuwe behandelingen, snelle diagnostiek en doeltreffende preventiemaatregelen.
Het Europese Partnership One Health Antimicrobial Resistance (EUP OHAMR) is opgericht binnen het Horizon Europe-programma. Het initiatief heeft als doel onderzoek en innovatie rond antimicrobiële resistentie (AMR) te versterken met een One Health-benadering, waarin mens, dier, voedselveiligheid en milieu onlosmakelijk met elkaar zijn verbonden.
Kernpunten
Het EUP OHAMR loopt van 2025 tot 2035 en richt zich op onderzoek, innovatie en beleidsafstemming rond antimicrobiële resistentie. Voor het programma is een budget van 250 miljoen euro beschikbaar, waarvan 75 miljoen euro afkomstig is van EU-cofinanciering. Het partnerschap vormt een breed programma dat onderzoek en vernieuwing ondersteunt die te maken hebben met capaciteitsversterking, kennisdeling, datagebruik en maatschappelijke impact.
De Zweedse Onderzoeksraad neemt de coördinatie van het programma op zich. EUP OHAMR bouwt hiermee voort op het succes van de Joint Programming Initiative on Antimicrobial Resistance (JPIAMR), dat sinds 2011 al meer dan 180 miljoen euro investeerde in AMR-onderzoek. Het volgens onderzoeksfinancierder ZonMw unieke en gratis toegangspunt, vergemakkelijkt kennisuitwisseling en het delen van AMR-gerelateerde onderzoeksdata voor de wereldwijde AMR-onderzoeksgemeenschap.
Zes implementatieprogramma’s
Binnen het nieuwe partnerschap zijn de activiteiten verdeeld over zes implementatieprogramma’s of werkpakketten, die elk worden geleid door een partnerorganisatie. Via deze structuur organiseert het partnerschap onder meer transnationale subsidieoproepen voor onderzoek en innovatie. Daarnaast worden trainingen en kennisactiviteiten opgezet om de impact te vergroten en de expertise en samenhang binnen de onderzoeksaanpak te versterken.
De impact van het programma wordt vergroot door bestaande data optimaal te hergebruiken en nieuwe onderzoeksgegevens beter beschikbaar te maken voor onderzoek naar antimicrobiële resistentie (AMR). Deze werkzaamheden vallen onder werkpakket 5 en worden uitgevoerd door ZonMw, in samenwerking met organisaties uit Spanje (IACS), Zwitserland (SNSF), Nederland (KIT), Bulgarije (HLSC) en Zweden (SRC).
Daarnaast vervult ZonMw binnen werkpakket 1 de rol van secretariaat van de Scientific Advisory Board (SAB) van het partnerschap. Ook neemt de organisatie deel aan internationale subsidieoproepen voor onderzoek en innovatie.